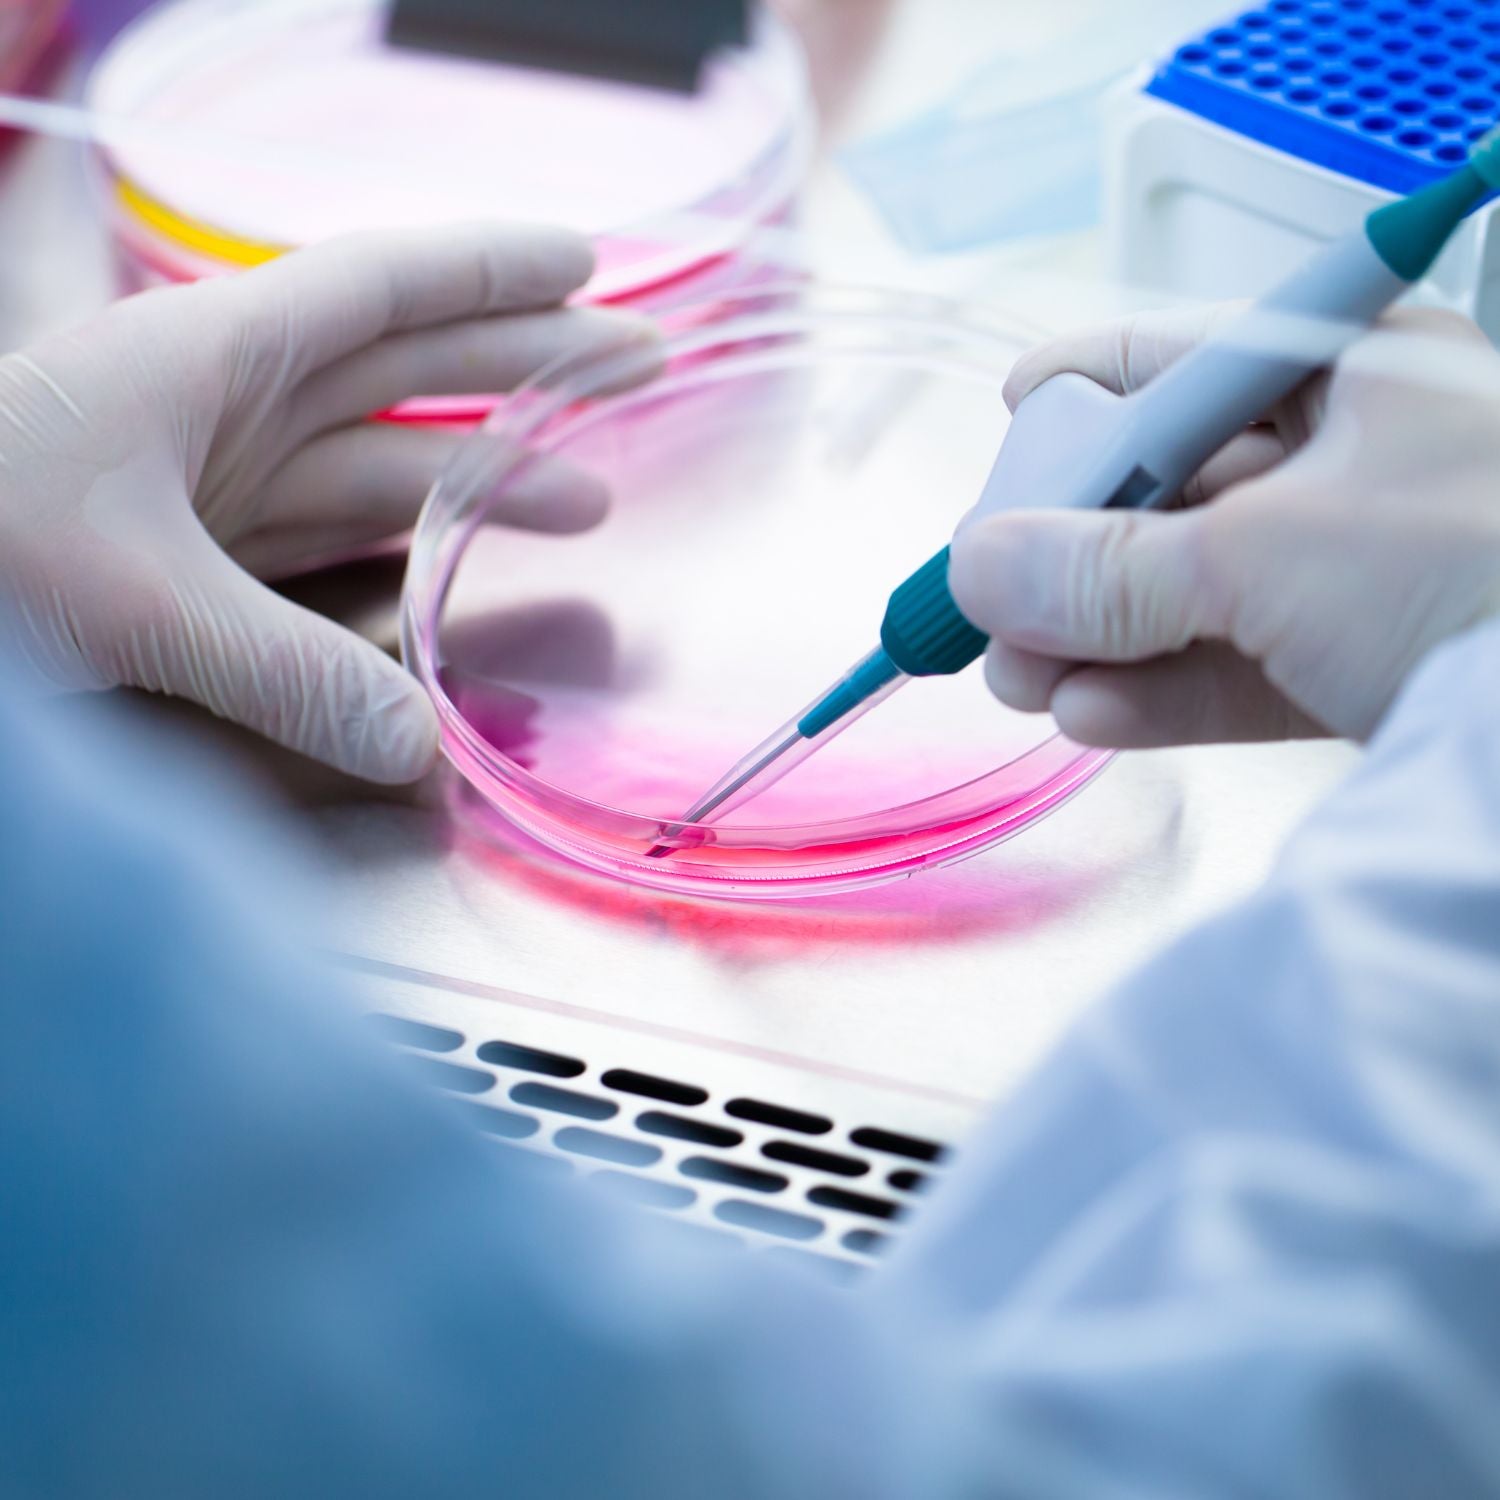

Cell-free human derived media
M-SEQNC
M-SEQNC (Media-Sequence) is a revolutionary cosmeceutical innovation that harnesses cell-free conditioned media derived from human umbilical cord mesenchymal stem cells. This complex mixture contains microvesicles, cytokines, peptides, and a full spectrum of growth factors, to enhance fibroblast functionality, accelerate cell proliferation, and promote deep skin regeneration.

Mesenchymal Stem Cells derived from the human umbilical cord tissue (hUC-MSC) are considered the richest and most effective source of MSCs. Studies have shown that hUC-MSCs have several properties that make them ideal for use in anti-aging and cell regenerative therapy. They secrete various growth factors and cytokines that significantly improves tissue regeneration, reduce inflammation, and promote cell proliferation. Additionally, hUC-MSCs can help enhance angiogenesis, the formation of new blood vessels, which is crucial for maintaining healthy tissue and combating age-related diseases.

Cell-free conditioned media (CFCM) is a complex mixture of proteins, growth factors, and other molecules secreted by cells cultured in a laboratory environment. Unlike traditional ingredients that involve the use of whole cells, CFCM only uses the byproducts of these cells. The process of creating cell-free conditioned media involves culturing specific types of cells (like fibroblasts, stem cells, or other cell lines) in controlled conditions. These cells release a cocktail of beneficial molecules into the surrounding media. After a set period, the media is collected, and the cells are removed, leaving behind a rich mixture of growth factors, cytokines, and other bioactive molecules.
Mesenchymal Stem Cells derived from the human umbilical cord tissue (hUC-MSC) are considered the richest and most effective source of MSCs. Studies have shown that hUC-MSCs have several properties that make them ideal for use in anti-aging and cell regenerative therapy. They secrete various growth factors and cytokines that significantly improves tissue regeneration, reduce inflammation, and promote cell proliferation. Additionally, hUC-MSCs can help enhance angiogenesis, the formation of new blood vessels, which is crucial for maintaining healthy tissue and combating age-related diseases.
Cell-free conditioned media (CFCM) is a complex mixture of proteins, growth factors, and other molecules secreted by cells cultured in a laboratory environment. Unlike traditional ingredients that involve the use of whole cells, CFCM only uses the byproducts of these cells. The process of creating cell-free conditioned media involves culturing specific types of cells (like fibroblasts, stem cells, or other cell lines) in controlled conditions. These cells release a cocktail of beneficial molecules into the surrounding media. After a set period, the media is collected, and the cells are removed, leaving behind a rich mixture of growth factors, cytokines, and other bioactive molecules.

M-SEQNC
The proprietary Media-Sequence (M-SEQNC) formula contains a myriad of bioactive molecules secreted by human umbilical cord mesenchymal stem cells (hUC-MSCs) during their growth and proliferation phase. These powerful signaling molecules play a crucial role in skin repair and regeneration.
Key Benefits

Immunomodulation
The secreted factors from hUC-MSCs can modulate the immune response in the skin, helping to regulate and balance immune activity. This can be particularly beneficial for conditions with immune system involvement, such as eczema or psoriasis.
Growth Factors & Cytokines
The secretome of hUC-MSCs contains various types of growth factors and cytokines that promote tissue repair and regeneration. By accelerating skin healing, these factors can minimize inflammation caused by injuries, wounds, or certain skin conditions.
Antioxidant Activity
hUC-MSCs release molecules with antioxidant properties, which can neutralize free radicals and oxidative stress in the skin. By reducing oxidative damage, these factors contribute to an overall anti-inflammatory effect.
Post-Treatment Recovery
The powerful regenerative properties of our M-SEQNC is clinically observed to help enhance your patients at home skin restoration process. Reducing overall recovery time and helping your patients attain tighter, healthier and firmer skin.
Collagen Stimulation
hUC-MSCs’ secretome can stimulate the production of collagen and other extracellular matrix components. This supports the skin’s structure and elasticity, potentially reducing inflammation caused by skin aging or environmental factors
Comparison between
hUC-MSCs | ASCs
Understanding the difference between SkinSeqnc™ proprietary source of Human Umbilical Cord Mesenchymal stem Cells versus traditional Adult Stem Cells
(hUC-MSC) Higher proliferation and expansion
(ASC) Lower proliferation and expansion
(hUC-MSC) Strong immunomodulatory effects
(ASC) Possess some immunomodulatory properties
(hUC-MSC) Can differentiate into various cell types
(ASC) Limited differentiation potential
(hUC-MSC) Obtained after birth without harm to the donor
(ASC) Obtained from tissues of adult individuals; ethical considerations
(hUC-MSC) Exhibit lower rates of senescence compared to adult stem cells
(ASC) Higher rate of senescence over time, lost efficacy to proliferate and differentiate